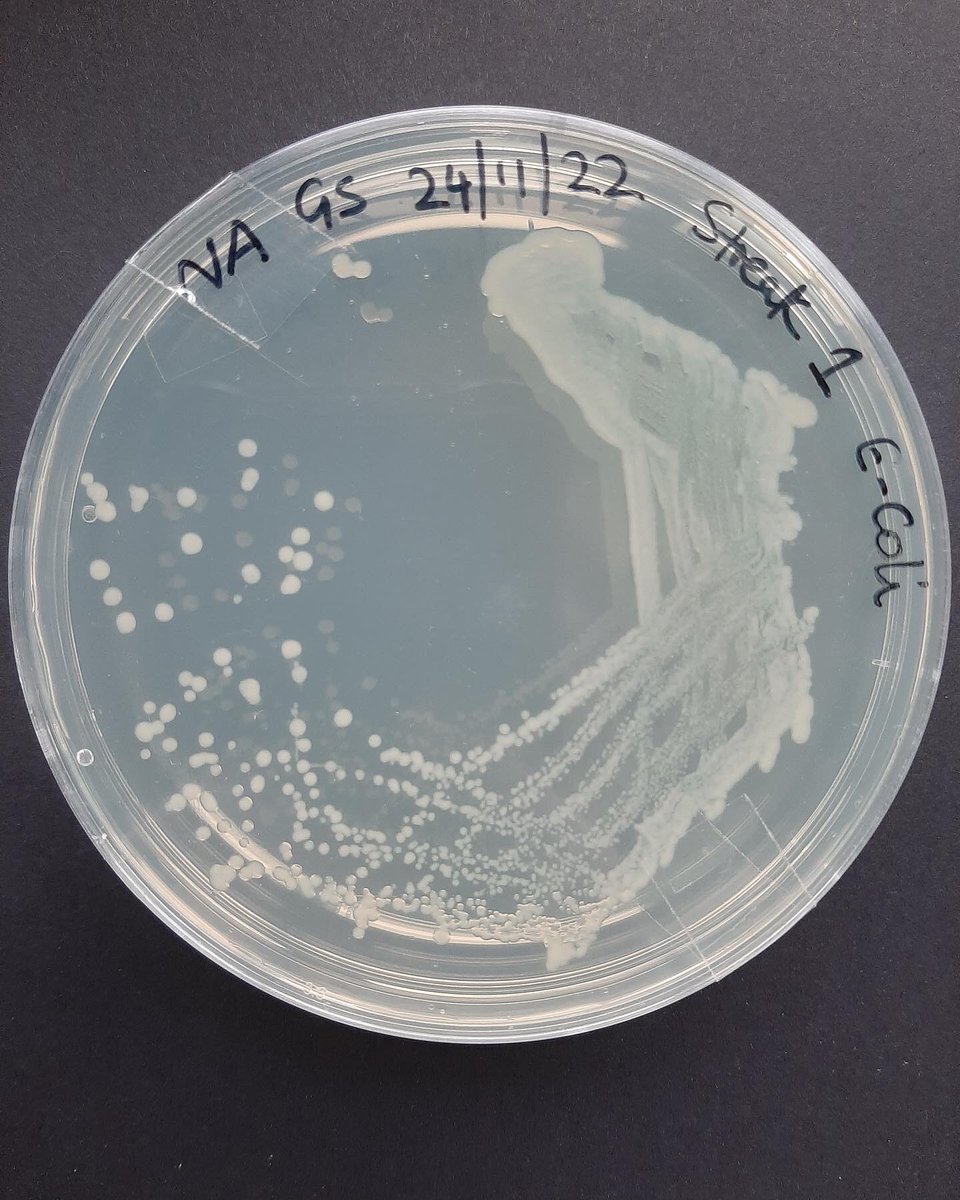
Mrs. Shah writes: Thank you to <a href="/Cleapss/">CLEAPSS 🏁</a> for organising a hands-on course for the technicians on 'Supporting Safe Practical Microbiology' last week at the St Clement Danes School.
Looking forward to more courses from Cleapss!

Gemini Shah RSciTech
@minigemshah
ID: 582019610
16-05-2012 17:36:07
82 Tweet
20 Followers
94 Following

Stanborough School Amgen 🧪🔬🧬 Amgen Biotech Experience (ABE) Program Office Centre for STEM Education Dr. Phil Smith Thank you to Amgen Biotech Experience (ABE) Program Office for the experience. Centre for STEM Education for organising all the fantastic equipment . Most of all, a huge thank-you to Gemini Shah RSciTech who organised and prepared all the labs on her own. Thanks Gemini for everything the students loved it! Can’t wait for next year!

Our A-level biologists, their teachers and our wonderful technician Gemini Shah RSciTech have all thoroughly enjoyed their Amgen Biotech Experience (ABE) Program Office biotech experience! 👏🏻👏🏻👏🏻

Gemini Shah RSciTech Elaine Mabbs Stanborough School Amgen 🧪🔬🧬 Amgen Biotech Experience (ABE) Program Office Dr. Phil Smith Well done Stanborough School, Gemini, Elaine, Cormac and your students. So glad it has been such a huge success.













Our Biologists checking the creation of a recombinant plasmid using Gel Electrophoresis which separates the DNA fragments. The gel is then stained to view the DNA bands of the Plasmid. The journey continues, using a PCR machine!#biotechexperience @ABEProgoffice Centre for STEM Education Dr. Phil Smith



Thank you to the students for their tireless effort and perseverance on the their first ever experience of DNA profiling! A BIG thank you to Amgen 🧪🔬🧬 Amgen Biotech Experience (ABE) Program Office Dr. Phil Smith Centre for STEM Education